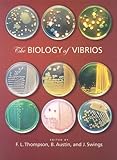

The Biology of Vibrios
The Biology of Vibrios
This book: provides comprehensive and authoritative coverage of vibrio research compiled by experts; presents new guidelines and paradigms for the different branches of vibrio research; features state-of-the-art coverage of a variety of disciplines, including taxonomy, pathogenesis, epidemiology, ecology, and genomics; and conveys important new developments and their impact on the study of vibrios.

List Price: $ 99.95
Price: $ 99.95
No comments:
Post a Comment